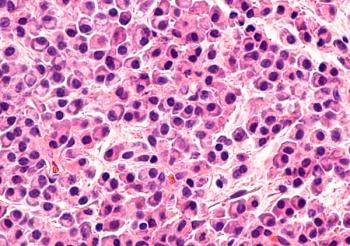

Combining talquetamab with teclistamab elicits responses even among those with extramedullary disease in the RedirecTT-1 trial.
Your AI-Trained Oncology Knowledge Connection!
Combining talquetamab with teclistamab elicits responses even among those with extramedullary disease in the RedirecTT-1 trial.
“We are now able to increase the lifespan in some of these most deadly forms of thyroid cancer solely due to gene profiling and targeted medicine,” said Geoffrey David Young, MD, PhD, FACS.
Samantha Shenoy, NP, MSN, discussed common oral and dermatologic adverse effects associated with talquetamab in patients with myeloma.
Eleven votes were cast against the favorability of using anti–PD-1 inhibitors in patients with ESCC and a PD-L1 expression of less than 1.
These findings demonstrate the potential risks associated with CNI-based immunosuppression in stem cell transplantation without concurrent strategies to eliminate alloreactive T cells.
In a multicenter study, researchers have a phase 1, open-label study of CB-012, a next-generation CRISPR-edited allogeneic anti-CLL-1 CAR-T cell therapy, aimed at treating adults with relapsed/refractory AML.
Extended follow-up from the CASSIOPEIA trial illustrates the PFS and MRD benefits of daratumumab-based induction/consolidation and maintenance therapy.
Ten votes were cast against PD-L1 as an efficacy biomarker for therapies intended to treat patients with gastric or GEJ adenocarcinoma.
Results from the ARANOTE trial support the supplemental new drug application for darolutamide/ADT in metastatic hormone-sensitive prostate cancer.
A subgroup analysis from the PERSEUS trial showed sustained PFS benefit in patients with newly diagnosed multiple myeloma receiving D-VRd.
Responses appear to improve over time in those with transplant-eligible newly diagnosed multiple who receive the belantamab mafodotin-based combination.
Data from a real-world study further illustrates clinical benefit in patients with cholangiocarcinoma receiving pemigatinib.
As the uterus is moved to the anterior abdominal wall, patients now have a chance of preserving their fertility during radiation therapy.
Findings from the phase 3 LAURA trial support the approval of osimertinib for advanced EGFR-mutated NSCLC.
Combination therapy with JAK inhibitors may help improve efficacy outcomes for patients with multiple myeloma.
The fixed-dose combination of favezelimab and pembrolizumab did not show an improvement in overall survival compared with the standard of care in patients with metastatic CRC.
Laura Bucher-Bailey, PharmD, discussed the approval of tisotumab vedotin-tftv for patients with recurrent or metastatic cervical cancer who have had progression after chemotherapy.
James R. Berenson, MD, discussed adverse effects associated with oral ruxolitinib plus selinexor in patients with multiple myeloma.
Phase 3 EV-302 results supported the approval, showing a statically significant survival benefit compared with chemotherapy in urothelial carcinoma.
Updated findings from the CARES-310 trial support the resubmitted application for camrelizumab/rivoceranib in unresectable hepatocellular carcinoma.
The approval is based on results from the global phase 3 FRESCO-2 trial, which demonstrated improvement in OS in patients with refractory metastatic colorectal cancer.
Carl He, MD, explores the barriers to adherence to treatment recommendations offered by the multidisciplinary team meeting in cancer care.
The act of asking for help is critical to finding mentors who can help one advance in the brain cancer field, according to Yoshie Umemura, MD.
Data from the GLOW and SPOTLIGHT trials support the European Commission’s approval of zolbetuximab for patients with CLDN18.2-positive gastric cancer.
A SEER-Medicare database analysis of patients with AML illustrates a trade-off between survival outcomes and time spent in hospitals.
Datopotamab deruxtecan previously showed statistically significant improvement in progression-free survival in patients with HR+, HER2-low, or HER2-negative breast cancer.
Nausheen Ahmed, MD, discusses the FDA REMS mandate to help assess toxicity in patients receiving CAR T-cell therapy.
Investigators of the Gliofocus trial look to set a clinically relevant “benchmark” in the glioblastoma field, according to Nader Sanai, MD.
Patients with HR-positive, HER2-positive breast cancer and high-risk features may derive benefit from ovarian function suppression plus endocrine therapy.
Amrita Y. Krishnan, MD, and Binod Dhakal, MD, gave a high-level overview of teclistamab use in the MajesTEC-1 trial.